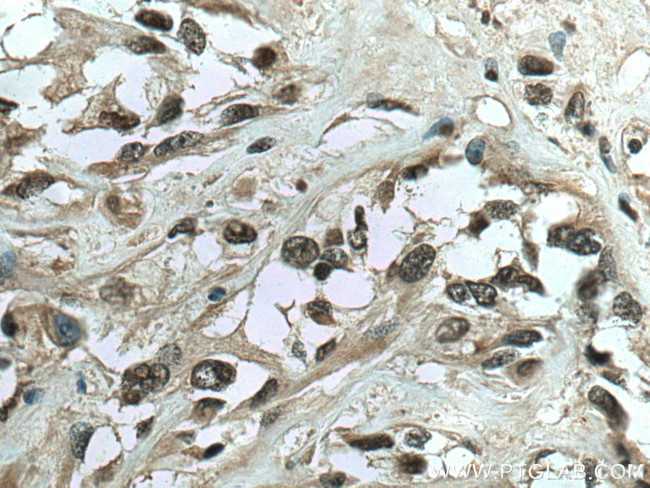
IFI16 Antibody in Immunohistochemistry (Paraffin) (IHC (P))

Search
Proteintech
IFI16 Polyclonal Antibody
{{$productOrderCtrl.translations['antibody.pdp.commerceCard.promotion.promotions']}}
{{$productOrderCtrl.translations['antibody.pdp.commerceCard.promotion.viewpromo']}}
{{$productOrderCtrl.translations['antibody.pdp.commerceCard.promotion.promocode']}}: {{promo.promoCode}} {{promo.promoTitle}} {{promo.promoDescription}}. {{$productOrderCtrl.translations['antibody.pdp.commerceCard.promotion.learnmore']}}
产品信息
29280-1-AP
种属反应
宿主/亚型
分类
类型
抗原
偶联物
形式
纯化类型
保存液
内含物
保存条件
运输条件
产品详细信息
Immunogen sequence: VCRNGFLEVY PFTLVADVNA DRNMEIPKGL IRSASVTPKI NQLCSQTKGS FVNGVFEVHK KNVRGEFTYY EIQDNTGKME VVVHGRLTTI NCEEGDKLKL TCFELAPKSG NTGELRSVIH SHIKVIKTRK NKKDILNPDS SMETSPDFFF
靶标信息
IFI16 (gamma-inteferon-inducible protein 16) binds double-stranded DNA. It binds preferentially to supercoiled DNA and cruciform DNA structures. It seems to be involved in transcriptional regulation and as a transcriptional repressor. IFI16 may have a role in the regulation of hematopoietic differentiation through activation of unknown target genes. It controls cellular proliferation by modulating the functions of cell cycle regulatory factors including p53/TP53 and the retinoblastoma protein. IFI16 is also involved in innate immune response by recognizing viral dsDNA in the cytosol and nucleus. After binding to viral DNA in the cytoplasm, IFI16 recruits TMEM173/STING and mediates the induction of IFN-beta. It is necessary to activate the IFR3 signaling cascade suring human herpes simplex virus 1 infection and promotes the assembly of heterochromatin on herpesviral DNA and inhibiton of viral immediate-early gene expression and replication. IFI16 is also involved in the MTA1-mediated epigenetic regulation of ESR1 expression in breast cancer.
仅用于科研。不用于诊断过程。未经明确授权不得转售。
篇参考文献 (0)
生物信息学
蛋白别名: Gamma-interferon-inducible protein 16; IFI 16C; Ifi-16; IFI16; interferon-gamma induced protein IFI 16; Interferon-inducible myeloid differentiation transcriptional activator; unnamed protein product
基因别名: IFI16; IFNGIP1; PYHIN2
UniProt ID: (Human) Q16666
Entrez Gene ID: (Human) 3428